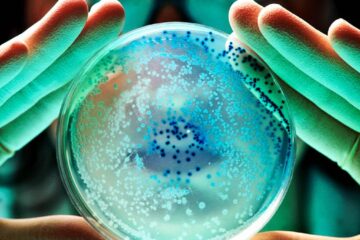
Cel puțin 10 cercetători implicați în proiecte sensibile au murit sau au dispărut în ultimii ani

O fabrică din Bistriţa-Năsăud concediază 500 de angajați! Șomajul explodează în iunie
Șomaj Bistrița-Năsăud: RAAL taie 500 joburi în iunie, detalii AJOFM
Criză majoră în industria auto din Bistrița-Năsăud. Un producător local de piese și accesorii pentru autovehicule și motoare anunță concedieri masive, care vor lovi peste 500 de familii începând cu a doua jumătate a anului 2026. Este al doilea val de disponibilizări la RAAL, după ce 250 de angajați au plecat deja la începutul anului. Impactul asupra ratei șomajului din județ devine inevitabil, cu semnale alarmante de pe piața muncii.
RAAL intră în colaps financiar: 500 de joburi pierdute în preaviz
Societatea RAAL, cu fabrici în Bistrița și Prundu Bârgăului, se confruntă cu probleme financiare grave, care duc la restructurări dure. Directoarea Agenției Județene pentru Ocuparea Forței de Muncă (AJOFM) Bistrița-Năsăud, Angela Koos, a confirmat notificarea finală primită săptămâna trecută.
„Ei sunt la faza de preaviz, ne-au notificat săptămâna trecută – notificarea finală. Începem serviciile de preconcediere şi, cu luna iunie, deci după ce expiră cele 30 de zile de preaviz, probabil că o să îi preluăm pe cei mai mulţi în şomaj. Este vorba despre 500 de persoane. Cu 250, care au fost anterior, deja sunt 750. Ei au acum pe organigramă 1.285 de angajaţi, din care pleacă 500 acum”, a declarat miercuri, pentru Agerpres, Angela Koos.
Aceste concedieri colective reduc organigrama RAAL cu peste o treime, lăsând în urmă sute de angajați cu familii dependente de salariile din industria auto. Problemele financiare ale companiei vin pe un fond național de scădere a cererii pentru piese auto, afectată de tranziția către vehicule electrice și de concurența internațională din Asia.
O altă lovitură: Firma de jocuri de noroc taie 40 de posturi
Nu doar sectorul industrial suferă. O companie din Bistrița, activă în domeniul jocurilor de noroc, a anunțat marți intenția de a concedia 40 de angajați din totalul de 165. Notificarea finală este așteptată în curând, conform surselor AJOFM.
Ea a adăugat că o altă firmă, de data aceasta din domeniul jocurilor de noroc, a anunţat marţi că intenţionează să renunţe la 40 dintre cei 165 de angajaţi, însă se aşteaptă notificarea finală.
Aceste disponibilizări vin într-un moment în care industria divertismentului este lovită de reglementări stricte și de schimbări în obiceiurile consumatorilor, care migrează spre platforme online reglementate diferit.
Rata șomajului în Bistrița-Năsăud: Scădere iluzorie în martie, explozie în iunie
Deși cifrele oficiale arată o ușoară îmbunătățire, realitatea este mult mai sumbră. Pentru luna martie 2026, rata șomajului a coborât la 3,53%, față de 3,58% în februarie – o scădere de doar 0,05 puncte procentuale. Totuși, experții avertizează că aceste date nu reflectă presiunea reală de pe piață.
„Rata şomajului a scăzut (în martie – n.r.) cu 0,05 puncte procentuale faţă de luna trecută. Acum este 3,53%, era 3,58% în februarie. Dar asta nu ne spune nimic, este exact partea intermediară între ce există pe piaţa muncii şi ce se va întâmpla de acum, deci clar o să crească, începând cu luna iunie se va simţi, pentru că oamenii încă sunt în preaviz, mai au timp să vină să se înregistreze la şomaj în termenul legal. Deci nu reflectă neapărat şomajul care există la ora actuală, nu reflectă neapărat persoanele inactive care sunt la ora actuală”, a explicat Koos.
Cu 750 de angajați RAAL plus alții din alte sectoare, șomajul tehnic se va transforma în șomaj oficial odată cu expirarea preavizelor. Județul Bistrița-Năsăud, cu o economie dependentă de producție industrială și servicii, riscă o criză socială majoră.
Piața muncii din Bistrița: Locuri de muncă tot mai puține, companii închise
Directoarea AJOFM subliniază că absorbția forței de muncă disponibilizate este imposibilă în actualul context. Locurile vacante se reduc, iar semnalele negative domină.
„La ora actuală, piaţa muncii nu este pregătită să îi integreze, ca număr de locuri vacante sunt tot mai puţine. Semnalele, în general, sunt de închidere a mai multor societăţi, mai mici, mai puţin mici, mai mari, dar în general observăm că deja vin câte doi, trei viitori şomeri, care se interesează ce acte o să le trebuiască, deci aşteptăm să fie în continuare, să se închidă activităţi. Marii contribuabili de la noi din judeţ deocamdată îşi conservă personalul, nu fac angajări”, a detaliat Koos.
Companiile mici închid porțile, iar giganții locali evită angajările noi. Sectoare precum HoReCa, construcții și agricultură ar putea absorbi temporar forța de muncă, dar nu la scară mare. Economia locală suferă de pe urma inflației persistente, costurilor energetice ridicate și scăderii exporturilor auto în UE.
Soluții de urgență: Bursa locurilor de muncă din mai 2026
Pentru a contracara criza, AJOFM Bistrița-Năsăud organizează în luna mai o bursă dedicată domeniilor cu deficit de personal: HoReCa, construcții și agricultură. Evenimentul vine exact la timp, înainte de valul de șomaj din iunie, oferind șanse reale celor afectați.
Participanții vor putea interacționa direct cu angajatori, beneficia de consiliere în carieră și cursuri de recalificare rapidă. Inițiativa face parte dintr-un pachet mai larg de sprijin guvernamental, inclusiv indemnizații de șomaj majorate și programe de reconversie profesională finanțate european.
Citește pe Antena3.ro
Crimă șocantă în Sectorul 3 din București: Un german de 86 de ani e suspectat că și-a sugrumat iubita de doar 30 de ani, cu o cârjă